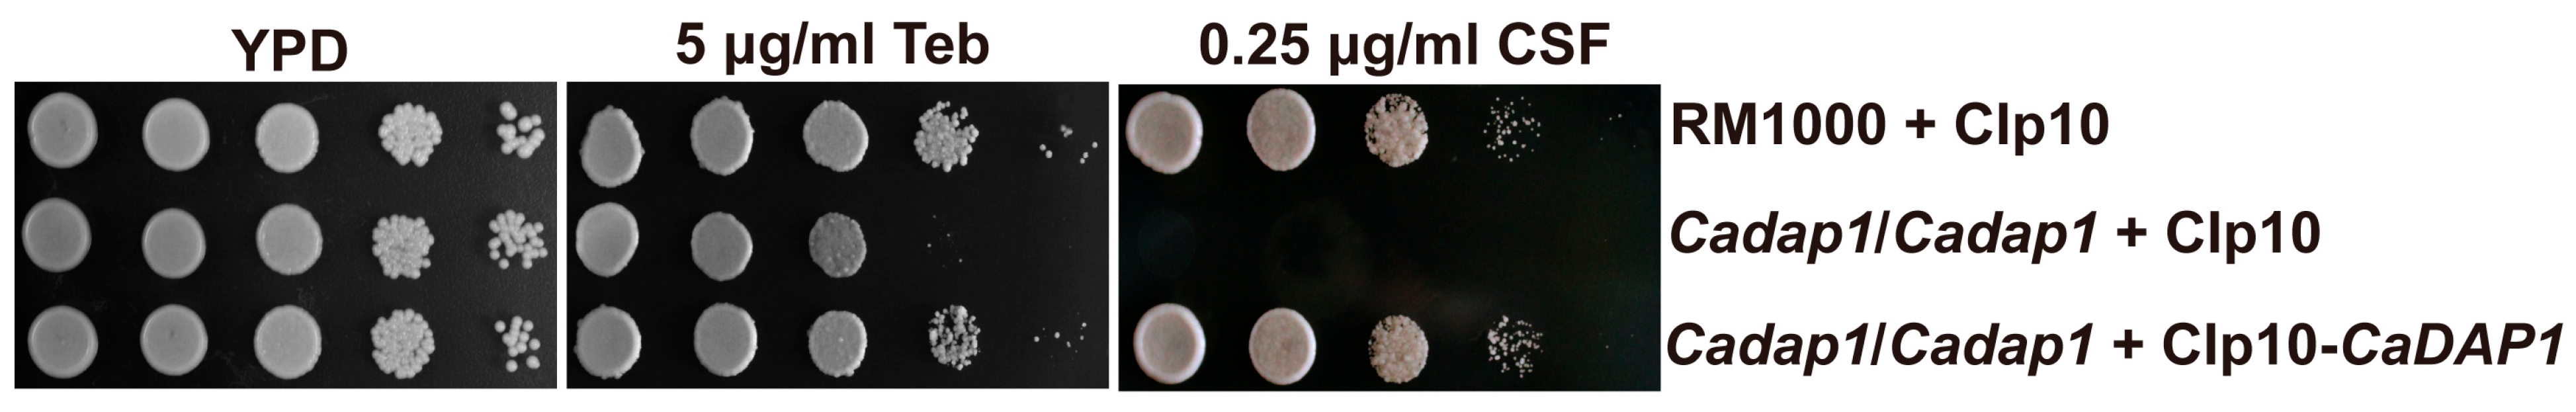

The Putative Cytochrome b5 Domain-Containing Protein CaDap1 Homologue Is Involved in Antifungal Drug Tolerance, Cell Wall Chitin Maintenance, and Virulence in Candida albicans
Abstract
1. Introduction
2. Materials and Methods
2.1. Strains, Media, Plasmids, and Primers
2.2. Construction of the Cadap1/Cadap1 Mutant and the Re-Integrant Strain (RS)
2.3. Growth Phenotypic Analysis and Hyphal Formation Examination
2.4. Measurement of Cell Wall Composition
- (1)
- Chitin quantification [28]
- (2)
- (3)
2.5. CFW Staining of Chitin and Fluorescence Microscopy
2.6. Quantitative Reverse Transcription PCR Analysis of CaCHS1, CaCHS2, CaCHS3, and CaCHS8
2.7. Protein Extraction and Western Blotting
2.8. Virulence Assay
2.9. Statistical Analysis
3. Results
3.1. Genomic Data Analysis
3.2. The Deletion of CaDAP1 Renders Ca Cells Susceptible to Caspofungin and Terbinafine
3.3. The Deletion of CaDAP1 Reduces the Chitin Content in Cell Walls, and Downregulates the Phosphorylation Levels of CaMkc1
3.4. Impact of CaDAP1 Deletion on Hyphal Development and Colony Morphology
3.5. The Deletion of CaDAP1 Affects the Virulence of Ca
4. Discussion
Supplementary Materials
Author Contributions
Funding
Institutional Review Board Statement
Informed Consent Statement
Data Availability Statement
Conflicts of Interest
References
- Gow, N.A.R.; van de Veerdonk, F.L.; Brown, A.J.P.; Netea, M.G. Candida albicans morphogenesis and host defence: Discriminating invasion from colonization. Nat. Rev. Microbiol. 2012, 10, 112–122. [Google Scholar] [CrossRef] [PubMed]
- Talapko, J.; Juzbasic, M.; Matijevic, T.; Pustijanac, E.; Bekic, S.; Kotris, I.; Skrlec, I. Candida albicans—The Virulence Factors and Clinical Manifestations of Infection. J. Fungi 2021, 7, 79. [Google Scholar] [CrossRef] [PubMed]
- Calderone, R.A.; Fonzi, W.A. Virulence factors of Candida albicans. Trends Microbiol. 2001, 9, 327–335. [Google Scholar] [CrossRef] [PubMed]
- Richardson, M.D. Changing patterns and trends in systemic fungal infections. J. Antimicrob. Chemother. 2005, 56 (Suppl. S1), i5–i11. [Google Scholar] [CrossRef] [PubMed]
- Mayer, F.L.; Wilson, D.; Hube, B. Candida albicans pathogenicity mechanisms. Virulence 2013, 4, 119–128. [Google Scholar] [CrossRef] [PubMed]
- Malinovská, Z.; Conková, E.; Váczi, P. Biofilm Formation in Medically Important Candida Species. J. Fungi 2023, 9, 955. [Google Scholar] [CrossRef] [PubMed]
- Gow Neil, A.R.; Latge, J.-P.; Munro Carol, A. The Fungal Cell Wall: Structure, Biosynthesis, and Function. Microbiol. Spectr. 2017, 5, 10–1128. [Google Scholar] [CrossRef]
- Lenardon, M.D.; Sood, P.; Dorfmueller, H.C.; Brown, A.J.P.; Gow, N.A.R. Scalar nanostructure of the Candida albicans cell wall; a molecular, cellular and ultrastructural analysis and interpretation. Cell Surf. 2020, 6, 100047. [Google Scholar] [CrossRef]
- Denning, D.W. Echinocandins: A new class of antifungal. J. Antimicrob. Chemother. 2002, 49, 889–891. [Google Scholar] [CrossRef] [PubMed]
- Hopke, A.; Brown, A.J.P.; Hall, R.A.; Wheeler, R.T. Dynamic Fungal Cell Wall Architecture in Stress Adaptation and Immune Evasion. Trends Microbiol. 2018, 26, 284–295. [Google Scholar] [CrossRef]
- Alves, R.; Barata-Antunes, C.; Casal, M.; Brown, A.J.P.; Van Dijck, P.; Paiva, S. Adapting to survive: How Candida overcomes host-imposed constraints during human colonization. PLoS Pathog. 2020, 16, e1008478. [Google Scholar] [CrossRef] [PubMed]
- Ibe, C.; Munro, C.A. Fungal Cell Wall Proteins and Signaling Pathways Form a Cytoprotective Network to Combat Stresses. J. Fungi 2021, 7, 739. [Google Scholar] [CrossRef] [PubMed]
- Lenardon, M.D.; Munro, C.A.; Gow, N.A. Chitin synthesis and fungal pathogenesis. Curr. Opin. Microbiol. 2010, 13, 416–423. [Google Scholar] [CrossRef]
- Mifsud, W.; Bateman, A. Membrane-bound progesterone receptors contain a cytochrome b5-like ligand-binding domain. Genome Biol. 2002, 3, RESEARCH0068. [Google Scholar] [CrossRef]
- Hand, R.A.; Jia, N.; Bard, M.; Craven, R.J. Saccharomyces cerevisiae Dap1p, a novel DNA damage response protein related to the mammalian membrane-associated progesterone receptor. Eukaryot. Cell 2003, 2, 306–317. [Google Scholar] [CrossRef] [PubMed]
- Mallory, J.C.; Crudden, G.; Johnson, B.L.; Mo, C.; Pierson, C.A.; Bard, M.; Craven, R.J. Dap1p, a heme-binding protein that regulates the cytochrome P450 protein Erg11p/Cyp51p in Saccharomyces cerevisiae. Mol. Cell. Biol. 2005, 25, 1669–1679. [Google Scholar] [CrossRef] [PubMed]
- Craven, R.J.; Mallory, J.C.; Hand, R.A. Regulation of iron homeostasis mediated by the heme-binding protein Dap1 (damage resistance protein 1) via the P450 protein Erg11/Cyp51. J. Biol. Chem. 2007, 282, 36543–36551. [Google Scholar] [CrossRef] [PubMed]
- Jo, W.J.; Kim, J.H.; Oh, E.; Jaramillo, D.; Holman, P.; Loguinov, A.V.; Arkin, A.P.; Nislow, C.; Giaever, G.; Vulpe, C.D. Novel insights into iron metabolism by integrating deletome and transcriptome analysis in an iron deficiency model of the yeast Saccharomyces cerevisiae. BMC Genom. 2009, 10, 130. [Google Scholar] [CrossRef] [PubMed]
- Hughes, A.L.; Powell, D.W.; Bard, M.; Eckstein, J.; Barbuch, R.; Link, A.J.; Espenshade, P.J. Dap1/PGRMC1 binds and regulates cytochrome P450 enzymes. Cell Metab. 2007, 5, 143–149. [Google Scholar] [CrossRef]
- Song, J.X.; Zhai, P.F.; Zhang, Y.W.; Zhang, C.Y.; Sang, H.; Han, G.Z.; Keller, N.P.; Lu, L. The Aspergillus fumigatus Damage Resistance Protein Family Coordinately Regulates Ergosterol Biosynthesis and Azole Susceptibility. mBio 2016, 7, 13. [Google Scholar] [CrossRef]
- Lee, C.-M.; Nantel, A.; Jiang, L.; Whiteway, M.; Shen, S.-H. The serine/threonine protein phosphatase SIT4 modulates yeast-to-hypha morphogenesis and virulence in Candida albicans. Mol. Microbiol. 2004, 51, 691–709. [Google Scholar] [CrossRef] [PubMed]
- Xu, D.Y.; Cheng, J.Q.; Cao, C.L.; Wang, L.T.; Jiang, L.H. Genetic interactions between Rch1 and the high-affinity calcium influx system Cch1/Mid1/Ecm7 in the regulation of calcium homeostasis, drug tolerance, hyphal development and virulence in Candida albicans. FEMS Yeast Res. 2015, 15, 9. [Google Scholar] [CrossRef]
- Xu, D.Y.; Zhang, X.; Zhang, B.; Zeng, X.; Mao, H.C.; Xu, H.T.; Jiang, L.H.; Li, F. The lipid flippase subunit Cdc50 is required for antifungal drug resistance, endocytosis, hyphal development and virulence in Candida albicans. FEMS Yeast Res. 2019, 19, 11. [Google Scholar] [CrossRef] [PubMed]
- Negredo, A.; Monteoliva, L.; Gil, C.; Pla, J.; Nombela, C. Cloning, analysis and one-step disruption of the ARG5,6 gene of Candida albicans. Microbiology 1997, 143 Pt 2, 297–302. [Google Scholar] [CrossRef]
- Reuss, O.; Vik, A.; Kolter, R.; Morschhauser, J. The SAT1 flipper, an optimized tool for gene disruption in Candida albicans. Gene 2004, 341, 119–127. [Google Scholar] [CrossRef] [PubMed]
- Wilson, R.B.; Davis, D.; Mitchell, A.P. Rapid hypothesis testing with Candida albicans through gene disruption with short homology regions. J. Bacteriol. 1999, 181, 1868–1874. [Google Scholar] [CrossRef] [PubMed]
- Murad, A.M.; Lee, P.R.; Broadbent, I.D.; Barelle, C.J.; Brown, A.J. CIp10, an efficient and convenient integrating vector for Candida albicans. Yeast 2000, 16, 325–327. [Google Scholar] [CrossRef]
- Jia, C.; Zhang, K.; Zhang, D.; Yu, Q.L.; Zhao, Q.; Xiao, C.P.; Dong, Y.J.; Chu, M.P.; Li, M.C. Roles of VPH2 and VMA6 in localization of V-ATPase subunits, cell wall functions and filamentous development in Candida albicans. Fungal Genet. Biol. 2018, 114, 1–11. [Google Scholar] [CrossRef] [PubMed]
- Watanabe, D.; Abe, M.; Ohya, Y. Yeast Lrg1p acts as a specialized RhoGAP regulating 1,3-beta-glucan synthesis. Yeast 2001, 18, 943–951. [Google Scholar] [CrossRef] [PubMed]
- Juchimiuk, M.; Orlowski, J.; Gawarecka, K.; Swiezewska, E.; Ernst, J.F.; Palamarczyk, G. Candida albicans cis-prenyltransferase Rer2 is required for protein glycosylation, cell wall integrity and hypha formation. Fungal Genet. Biol. 2014, 69, 1–12. [Google Scholar] [CrossRef]
- Walker, L.A.; Munro, C.A.; de Bruijn, I.; Lenardon, M.D.; McKinnon, A.; Gow, N.A.R. Stimulation of chitin synthesis rescues Candida albicans from echinocandins. PLoS Pathog. 2008, 4, e1000040. [Google Scholar] [CrossRef] [PubMed]
- Huang, X.H.; Chen, X.Q.; He, Y.M.; Yu, X.Y.; Li, S.S.; Gao, N.; Niu, L.D.; Mao, Y.H.; Wang, Y.Y.; Wu, X.W.; et al. Mitochondrial complex I bridges a connection between regulation of carbon flexibility and gastrointestinal commensalism in the human fungal pathogen Candida albicans. PLoS Pathog. 2017, 13, 35. [Google Scholar] [CrossRef] [PubMed]
- Chen, C.B.; Pande, K.; French, S.D.; Tuch, B.B.; Noble, S.M. An Iron Homeostasis Regulatory Circuit with Reciprocal Roles in Candida albicans Commensalism and Pathogenesis. Cell Host Microbe 2011, 10, 118–135. [Google Scholar] [CrossRef] [PubMed]
- Denning, D.W. Echinocandin antifungal drugs. Lancet 2003, 362, 1142–1151. [Google Scholar] [CrossRef] [PubMed]
- Perlin, D.S. Current perspectives on echinocandin class drugs. Future Microbiol. 2011, 6, 441–457. [Google Scholar] [CrossRef] [PubMed]
- Munro, C.A.; Selvaggini, S.; de Bruijn, I.; Walker, L.; Lenardon, M.D.; Gerssen, B.; Milne, S.; Brown, A.J.P.; Gow, N.A.R. The PKC, HOG and Ca2+ signalling pathways co-ordinately regulate chitin synthesis in Candida albicans. Mol. Microbiol. 2007, 63, 1399–1413. [Google Scholar] [CrossRef] [PubMed]
- Lenardon, M.D.; Milne, S.A.; Mora-Montes, H.M.; Kaffarnik, F.A.R.; Peck, S.C.; Brown, A.J.P.; Munro, C.A.; Gow, N.A.R. Phosphorylation regulates polarisation of chitin synthesis in Candida albicans. J. Cell Sci. 2010, 123, 2199–2206. [Google Scholar] [CrossRef] [PubMed][Green Version]
- Hosogaya, N.; Miyazaki, T.; Nagi, M.; Tanabe, K.; Minematsu, A.; Nagayoshi, Y.; Yamauchi, S.; Nakamura, S.; Imamura, Y.; Izumikawa, K.; et al. The heme-binding protein Dap1 links iron homeostasis to azole resistance via the P450 protein Erg11 in Candida glabrata. FEMS Yeast Res. 2013, 13, 411–421. [Google Scholar] [CrossRef] [PubMed]
- Han, Q.; Wang, N.; Pan, C.Y.; Wang, Y.; Sang, J.L. Elevation of cell wall chitin via Ca2+-calcineurin-mediated PKC signaling pathway maintains the viability of Candida albicans in the absence of β-1,6-glucan synthesis. Mol. Microbiol. 2019, 112, 960–972. [Google Scholar] [CrossRef]
- Bulawa, C.E.; Miller, D.W.; Henry, L.K.; Becker, J.M. Attenuated virulence of chitin-deficient mutants of Candida albicans. Proc. Natl. Acad. Sci. USA 1995, 92, 10570–10574. [Google Scholar] [CrossRef] [PubMed]
- Wagener, J.; MacCallum, D.M.; Brown, G.D.; Gow, N.A.R. Candida albicans Chitin Increases Arginase-1 Activity in Human Macrophages, with an Impact on Macrophage Antimicrobial Functions. mBio 2017, 8, 14. [Google Scholar] [CrossRef] [PubMed]
- Rowbottom, L.; Munro, C.A.; Gow, N.A.R. Candida albicans mutants in the BNI4 gene have reduced cell-wall chitin and alterations in morphogenesis. Microbiology 2004, 150, 3243–3252. [Google Scholar] [CrossRef] [PubMed]
- Mio, T.; Yabe, T.; Sudoh, M.; Satoh, Y.; Nakajima, T.; Arisawa, M.; Yamada-Okabe, H. Role of three chitin synthase genes in the growth of Candida albicans. J. Bacteriol. 1996, 178, 2416–2419. [Google Scholar] [CrossRef] [PubMed]
- Knafler, H.C.; Smaczynska-de Rooij, I.I.; Walker, L.A.; Lee, K.K.; Gow, N.A.R.; Ayscough, K.R. AP-2-Dependent Endocytic Recycling of the Chitin Synthase Chs3 Regulates Polarized Growth in Candida albicans. mBio 2019, 10, 20. [Google Scholar] [CrossRef] [PubMed]
- Lee, K.K.; MacCallum, D.M.; Jacobsen, M.D.; Walker, L.A.; Odds, F.C.; Gow, N.A.R.; Munro, C.A. Elevated Cell Wall Chitin in Candida albicans Confers Echinocandin Resistance In Vivo. Antimicrob. Agents Chemother. 2012, 56, 208–217. [Google Scholar] [CrossRef] [PubMed]
- Walker, L.A.; Gow, N.A.R.; Munro, C.A. Elevated Chitin Content Reduces the Susceptibility of Candida Species to Caspofungin. Antimicrob. Agents Chemother. 2013, 57, 146–154. [Google Scholar] [CrossRef] [PubMed]

| Strains and Plasmids | Genotype | Source |
|---|---|---|
| C. albicans strains | ||
| RM1000 | ura3::λimm434/ura3::λimm434 his1:: hisG/his1::hisG | [24] |
| Cadap1/Cadap1 | RM1000 Cadap1::HIS1/Cadap1:: FRT | This study |
| RM1000+CIp10 | RM1000 RPS1/rps1::CIp10 | [23] |
| Cadap1/Cadap1+CIp10 | RM1000 Cadap1::HIS1/Cadap1:: FRT RPS1/rps1::CIp10 | This study |
| Cadap1/Cadap1+ CIp10-CaDAP1 | RM1000 Cadap1::HIS1/Cadap1:: FRT RPS1/rps1::CIp10-CaDAP1 | This study |
| Plasmids | ||
| pSFS2 | SAT1 flipper cassette, Ampr | [25] |
| pGEM-HIS1 | HIS1 cassettes, Ampr | [26] |
| CIp10 | Integrating vector for C. albicans, URA3, Ampr | [27] |
| CIp10-CaDAP1 | Full-length CaDAP1 gene in CIp10 | This study |
| Primer Name | Sequence (5’–3’) | Restriction Site |
|---|---|---|
| DAP1-NAT-UP | TGGAGACTACATATATTAAGTCACATATATAAATGCACGTACTTTTTTTTTCTTCACACACACCACCAAACATACTAACGCGATCCTTAAATCAACCATCAATTAACCCTCACTAAAGGG | |
| DAP1-NAT-DOWN | AATATAGACCTAGATATATGCATAACGTTTTTTAATTTTTCCCTATTAATATTATTAAATGTCTCTATTAATGCATTCCGGGGAACTTCATATGTTCACAAATACGACTCACTATAGGG | |
| DAP1-HIS-UP | TGGAGACTACATATATTAAGTCACATATATAAATGCACGTACTTTTTTTTTCTTCACACACACCACCAAACATACTAACGCGATCCTTAAATCAACCATCGGCCAGTGAATTGTAATACG | |
| DAP1-HIS-DOWN | AATATAGACCTAGATATATGCATAACGTTTTTTAATTTTTCCCTATTAATATTATTAAATGTCTCTATTAATGCATTCCGGGGAACTTCATATGTTCACACAAGTTGAACTCCCTTATGG | |
| DAP1-UP-CHECK | CAAGAGTCAAGAAAGGAAAGC | |
| DAP1-DOWN-CHECK | TGAAGGTGGTGGTTATGGAG | |
| DAP1-ORF-UP | TTCAACATGGGGGTATCGAG | |
| DAP1-ORF-DOWN | CCAGTAACATAAACTCTAGCTGC | |
| DAP1-UP-CLO | CGCGAGCTCTACCACCCCTTCCTTACATC | SacI |
| DAP1-DOWN-CLO | AAGGAAAAAAGCGGCCGCAACGCAGTAAATCTTCACAAGG | NotI |
| qCaACT1-F | GAAGCCCAATCCAAAAGAG | |
| qCaACT1-R | CTTCTGGAGCAACTCTCAATTC | |
| qCaCHS1-F | CTCTCGAGAAACATTTGCTG | |
| qCaCHS1-R | GTAGTTTCAGGACTGGCATC | |
| qCaCHS2-F | CACTTCTCAAACACAGATCC | |
| qCaCHS2-R | CATGAGATGATTAGGTTGACC | |
| qCaCHS3-F | TCACCCAGATGTTGTTCCTC | |
| qCaCHS3-R | GAGAATTAGGGTAATCGGTGG | |
| qCaCHS8-F | TGTTAGAAGCTGGTGGAGTC | |
| qCaCHS8-R | CATTTAAGTGGACGGAAACTC |
Disclaimer/Publisher’s Note: The statements, opinions and data contained in all publications are solely those of the individual author(s) and contributor(s) and not of MDPI and/or the editor(s). MDPI and/or the editor(s) disclaim responsibility for any injury to people or property resulting from any ideas, methods, instructions or products referred to in the content. |
© 2024 by the authors. Licensee MDPI, Basel, Switzerland. This article is an open access article distributed under the terms and conditions of the Creative Commons Attribution (CC BY) license (https://creativecommons.org/licenses/by/4.0/).
Share and Cite
Xu, D.; Wang, M.; Zhang, X.; Mao, H.; Xu, H.; Zhang, B.; Zeng, X.; Li, F. The Putative Cytochrome b5 Domain-Containing Protein CaDap1 Homologue Is Involved in Antifungal Drug Tolerance, Cell Wall Chitin Maintenance, and Virulence in Candida albicans. J. Fungi 2024, 10, 316. https://doi.org/10.3390/jof10050316
Xu D, Wang M, Zhang X, Mao H, Xu H, Zhang B, Zeng X, Li F. The Putative Cytochrome b5 Domain-Containing Protein CaDap1 Homologue Is Involved in Antifungal Drug Tolerance, Cell Wall Chitin Maintenance, and Virulence in Candida albicans. Journal of Fungi. 2024; 10(5):316. https://doi.org/10.3390/jof10050316
Chicago/Turabian StyleXu, Dayong, Manman Wang, Xing Zhang, Hongchen Mao, Haitao Xu, Biao Zhang, Xin Zeng, and Feng Li. 2024. "The Putative Cytochrome b5 Domain-Containing Protein CaDap1 Homologue Is Involved in Antifungal Drug Tolerance, Cell Wall Chitin Maintenance, and Virulence in Candida albicans" Journal of Fungi 10, no. 5: 316. https://doi.org/10.3390/jof10050316
APA StyleXu, D., Wang, M., Zhang, X., Mao, H., Xu, H., Zhang, B., Zeng, X., & Li, F. (2024). The Putative Cytochrome b5 Domain-Containing Protein CaDap1 Homologue Is Involved in Antifungal Drug Tolerance, Cell Wall Chitin Maintenance, and Virulence in Candida albicans. Journal of Fungi, 10(5), 316. https://doi.org/10.3390/jof10050316
